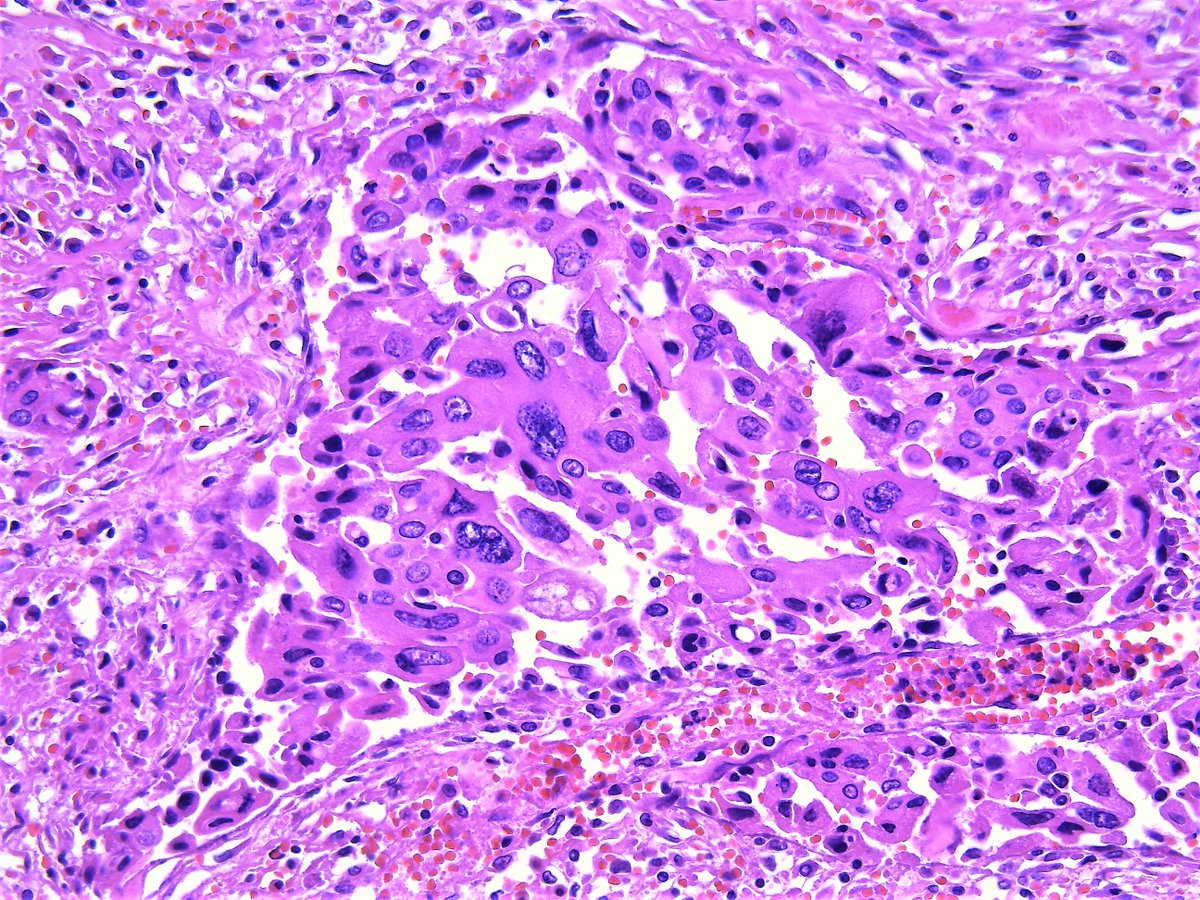

Pathology Outlines Anaplastic Carcinoma
anaplastic thyroid cancer histology is free HD wallpaper was upload by Admin. Download this image for free in HD resolution the choice "download button" below. If you do not find the exact resolution you are looking for, then go for a native or higher resolution.
Don't forget to bookmark anaplastic thyroid cancer histology using Ctrl + D (PC) or Command + D (macos). If you are using mobile phone, you could also use menu drawer from browser. Whether it's Windows, Mac, iOs or Android, you will be able to download the images using download button.
Pathology Outlines Anaplastic Carcinoma
Pathology Outlines Anaplastic Carcinoma
Pathology Outlines Anaplastic Carcinoma
 Anaplastic Thyroid Cancer Wikipedia
Anaplastic Thyroid Cancer Wikipedia
Pathology Outlines Anaplastic Carcinoma
Pathology Outlines Anaplastic Carcinoma
Poorly Differentiated And Undifferentiated Thyroid Carcinomas
 A Large Nonmetastatic Anaplastic Thyroid Cancer With
A Large Nonmetastatic Anaplastic Thyroid Cancer With
Pathology Outlines Anaplastic Carcinoma
 A Large Nonmetastatic Anaplastic Thyroid Cancer With
A Large Nonmetastatic Anaplastic Thyroid Cancer With
 Anaplastic Thyroid Cancer Diagnosis
Anaplastic Thyroid Cancer Diagnosis
 Anaplastic Carcinoma An Overview Sciencedirect Topics
Anaplastic Carcinoma An Overview Sciencedirect Topics
Pathology Outlines Anaplastic Carcinoma
 Thyroid Cancer Types Management
Thyroid Cancer Types Management
Anaplastic Thyroid Cancer Patients Live Longer With
 Braf Mutations In Anaplastic Thyroid Carcinoma Implications
Braf Mutations In Anaplastic Thyroid Carcinoma Implications
Clinico Pathological Profile Of Anaplastic Thyroid Carcinoma
 Medullary Thyroid Cancer Wikipedia
Medullary Thyroid Cancer Wikipedia
 These Slides Illustrate The Various Histologic Features Of
These Slides Illustrate The Various Histologic Features Of
Pathology Outlines Poorly Differentiated Thyroid Carcinoma
 Medullary Thyroid Carcinoma Libre Pathology
Medullary Thyroid Carcinoma Libre Pathology
 Anaplastic Thyroid Cancer Diagnosis
Anaplastic Thyroid Cancer Diagnosis
 Anaplastic Carcinoma An Overview Sciencedirect Topics
Anaplastic Carcinoma An Overview Sciencedirect Topics
 Dictionary Pathology Thyroid Cancer The Human Protein Atlas
Dictionary Pathology Thyroid Cancer The Human Protein Atlas

Pathology Outlines Poorly Differentiated Thyroid Carcinoma
Poorly Differentiated And Anaplastic Thyroid Cancer
Anaplastic Carcinoma Thyroid Histology
 Histology Of Anaplastic Thyroid Carcinoma Hematoxylin And
Histology Of Anaplastic Thyroid Carcinoma Hematoxylin And
Pathology Outlines Anaplastic Carcinoma
 Thyroid Gland Malignancies Oncohema Key
Thyroid Gland Malignancies Oncohema Key
 Figure 2 From Anaplastic Thyroid Carcinoma From
Figure 2 From Anaplastic Thyroid Carcinoma From
 Thyroid Cancer Genetics Study Finds New Mutations
Thyroid Cancer Genetics Study Finds New Mutations
 Tumors Of The Thyroid Gland Ppt Video Online Download
Tumors Of The Thyroid Gland Ppt Video Online Download
 Thyroid Papillary Thyroid Cancer Pathology
Thyroid Papillary Thyroid Cancer Pathology
 Papillary Thyroid Carcinoma Iowa Head And Neck Protocols
Papillary Thyroid Carcinoma Iowa Head And Neck Protocols
 Pharmacological Inhibition Of Intracellular Signaling
Pharmacological Inhibition Of Intracellular Signaling
 Recurrence Of Thyroid Cancer From Papillary To Anaplastic
Recurrence Of Thyroid Cancer From Papillary To Anaplastic
 Anaplastic Thyroid Carcinoma An Epidemiologic Histologic
Anaplastic Thyroid Carcinoma An Epidemiologic Histologic
Thyroid Slide Leyme Carpentersdaughter Co
 Intercellular Adhesion Molecule 1 Is A Sensitive And
Intercellular Adhesion Molecule 1 Is A Sensitive And
Pathology Outlines Poorly Differentiated Thyroid Carcinoma
Classification And General Considerations Of Thyroid Cancer
 Thyroid Cancers Fertilitypedia
Thyroid Cancers Fertilitypedia
 Follicular Thyroid Cancer Wikipedia
Follicular Thyroid Cancer Wikipedia
 Pathology Of The Thyroid Gland
Pathology Of The Thyroid Gland
 Thyroid Cancer Oncology Medbullets Step 1
Thyroid Cancer Oncology Medbullets Step 1
Pathology Outlines Anaplastic Carcinoma
2 Poorly Differentiated And Anaplastic Thyroid Carinoma
Special Types Of Thyroid Carcinoma

The Histological Rarity Of Thyroid Cancer
 Response And Acquired Resistance To Everolimus In Anaplastic
Response And Acquired Resistance To Everolimus In Anaplastic
Special Types Of Thyroid Carcinoma
 Figure 9 From Histopathology Of C Cells And Medullary
Figure 9 From Histopathology Of C Cells And Medullary
2 Poorly Differentiated And Anaplastic Thyroid Carinoma
 Aggressive Variants Of Follicular And Parafollicular Derive
Aggressive Variants Of Follicular And Parafollicular Derive
 A And B Aspirates From Anaplastic Thyroid Carcinoma Show
A And B Aspirates From Anaplastic Thyroid Carcinoma Show
 Dictionary Cancer Thyroid Cancer The Human Protein Atlas
Dictionary Cancer Thyroid Cancer The Human Protein Atlas
Special Types Of Thyroid Carcinoma
Pathology Outlines Papillary Carcinoma General
Classification And General Considerations Of Thyroid Cancer
 Treatment Outcomes In Anaplastic Thyroid Cancer
Treatment Outcomes In Anaplastic Thyroid Cancer
Pathologic Prognosis Factors In Papillary Thyroid Carcinoma
 Papillary Thyroid Cancer Wikipedia
Papillary Thyroid Cancer Wikipedia
 Thyroid Cancer Flashcards Quizlet
Thyroid Cancer Flashcards Quizlet
2 Poorly Differentiated And Anaplastic Thyroid Carinoma
Thyroid Thyroid Gland Pathology Ppt
Thyroid Thyroid Gland Pathology Ppt
 Sarcomatoid Carcinoma Of The Thyroid Report Of A Subtype Of
Sarcomatoid Carcinoma Of The Thyroid Report Of A Subtype Of
Special Types Of Thyroid Carcinoma
 Thyroid And Parathyroid Glands Basicmedical Key
Thyroid And Parathyroid Glands Basicmedical Key
Classification And General Considerations Of Thyroid Cancer
 Anaplastic Thyroid Carcinoma Practice Essentials
Anaplastic Thyroid Carcinoma Practice Essentials
 A 61 Year Old Woman With An Incidental Finding In A Thyroid
A 61 Year Old Woman With An Incidental Finding In A Thyroid
 Papillary Thyroid Carcinoma An Update Modern Pathology
Papillary Thyroid Carcinoma An Update Modern Pathology
 Case N 09 Medullary Thyroid Carcinoma Cytology Blog Site
Case N 09 Medullary Thyroid Carcinoma Cytology Blog Site
Pathology Outlines Papillary Carcinoma General
 Diagnosis Of Papillary Thyroid Cancer
Diagnosis Of Papillary Thyroid Cancer
 Projected Incidence Of Thyroid Cancer Overall And For
Projected Incidence Of Thyroid Cancer Overall And For
Review Article Update On Anaplastic Thyroid Carcinoma
Thyroid Leiomyosarcoma Presentation Of Two Cases And Review
Special Types Of Thyroid Carcinoma
 Webpathology Com A Collection Of Surgical Pathology Images
Webpathology Com A Collection Of Surgical Pathology Images
Application Of Immunohistochemistry In Thyroid Pathology
Anaplastic Carcinoma Of The Thyroid Clinico Morphological
 Dictionary Pathology Thyroid Cancer The Human Protein Atlas
Dictionary Pathology Thyroid Cancer The Human Protein Atlas
 Thyroid Nodules In Diagnostic Pathology From Classic
Thyroid Nodules In Diagnostic Pathology From Classic
Diagnosis Of Anaplastic Thy Fine Needle Aspiration Cyto
Review Article Update On Anaplastic Thyroid Carcinoma
 Igf Ir Expression In Human Thyroid Cancer Tissue Arrays And
Igf Ir Expression In Human Thyroid Cancer Tissue Arrays And
 Sarcomatoid Carcinoma Of The Thyroid Report Of A Subtype Of
Sarcomatoid Carcinoma Of The Thyroid Report Of A Subtype Of
 Expression And Function Of Cxcl12 Cxcr4 Cxcr7 In Thyroid Cancer
Expression And Function Of Cxcl12 Cxcr4 Cxcr7 In Thyroid Cancer



